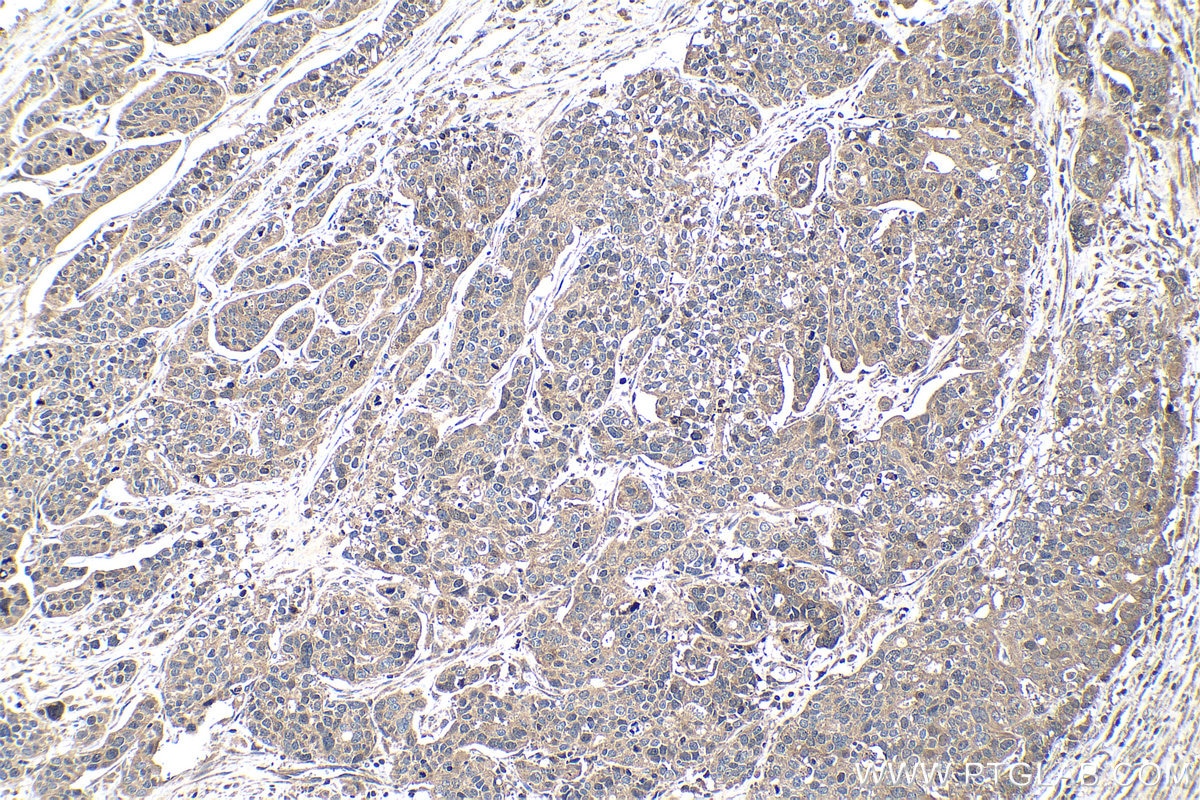
Immunohistochemistry (IHC) staining of human ovary tumor tissue using BRCA1 Polyclonal antibody (22362-1-AP)

Tested Applications
| Positive WB detected in | MCF-7 cells |
| Positive IP detected in | MCF-7 cells |
| Positive IHC detected in | human ovary tumor tissue, human breast cancer tissue, human lung cancer tissue Note: suggested antigen retrieval with TE buffer pH 9.0; (*) Alternatively, antigen retrieval may be performed with citrate buffer pH 6.0 |
Recommended dilution
| Application | Dilution |
|---|---|
| Western Blot (WB) | WB : 1:1000-1:4000 |
| Immunoprecipitation (IP) | IP : 0.5-4.0 ug for 1.0-3.0 mg of total protein lysate |
| Immunohistochemistry (IHC) | IHC : 1:500-1:2000 |
| It is recommended that this reagent should be titrated in each testing system to obtain optimal results. | |
| Sample-dependent, Check data in validation data gallery. | |
Published Applications
| KD/KO | See 5 publications below |
| WB | See 48 publications below |
| IHC | See 8 publications below |
| IF | See 7 publications below |
| IP | See 1 publications below |
| ChIP | See 2 publications below |
Product Information
22362-1-AP targets BRCA1 in WB, IHC, IF, IP, ChIP, ELISA applications and shows reactivity with human samples.
| Tested Reactivity | human |
| Cited Reactivity | human |
| Host / Isotype | Rabbit / IgG |
| Class | Polyclonal |
| Type | Antibody |
| Immunogen |
CatNo: Ag17946 Product name: Recombinant human BRCA1 protein Source: e coli.-derived, PGEX-4T Tag: GST Domain: 1514-1863 aa of BC115037 Sequence: SGSLQNRNYPSQEGLIKVVDVEEQQLEESGPHDLTETSYLPRQDLEGTPYLESGISLFSDDPESDPSEDRAPESARVGNIPSSTSALKVPQLKVAESAQGPAAAHTTDTAGYNAMEESVSREKPELTASTERVNKRMSIVVSGLTPEEFMLVYKFARKHHITLTNLITEETTHVVMKTDAEFVCERTLKYFLGIAGGKWVVSYFWVTQSIKERKMLNEHDFEVRGDVVNGRNHQGPKRARESQDRKIFRGLEICCYGPFTNMPTDQLEWMVQLCGASVVKELSSFTLGTGVHPIVVVQPDAWTEDNGFHAIGQMCEAPVVTREWVLDSVALYQCQELDTYLIPQIPHSHY Predict reactive species |
| Full Name | breast cancer 1, early onset |
| Calculated Molecular Weight | 1863 aa, 208 kDa |
| Observed Molecular Weight | 300 kDa |
| GenBank Accession Number | BC115037 |
| Gene Symbol | BRCA1 |
| Gene ID (NCBI) | 672 |
| RRID | AB_2879090 |
| Conjugate | Unconjugated |
| Form | Liquid |
| Purification Method | Antigen affinity purification |
| UNIPROT ID | P38398 |
| Storage Buffer | PBS with 0.02% sodium azide and 50% glycerol, pH 7.3. |
| Storage Conditions | Store at -20°C. Stable for one year after shipment. Aliquoting is unnecessary for -20oC storage. 20ul sizes contain 0.1% BSA. |
Background Information
BRCA1, also named as RNF53, plays a central role in DNA repair by facilitating cellular response to DNA repair. It is required for appropriate cell cycle arrests after ionizing irradiation in both the S-phase and the G2 phase of the cell cycle. The BRCA1-BARD1 heterodimer coordinates a diverse range of cellular pathways such as DNA damage repair, ubiquitination and transcriptional regulation to maintain genomic stability. BRCA1 acts by mediating ubiquitin E3 ligase activity that is required for its tumor suppressor function. It is involved in transcriptional regulation of P21 in response to DNA damage. BRCA1 is required for FANCD2 targeting to sites of DNA damage. It may function as a transcriptional regulator. BRCA1 inhibits lipid synthesis by binding to inactive phosphorylated ACACA and preventing its dephosphorylation. The antibody is specific to BRCA1. BRCA1 appears to produce multiple splice variants. BRCA1 is a nuclear protein with a molecular mass of 220 kDa. The present study describes the isolation and expression of two cDNAs of BRCA1, including a splice variant designated BRCA1D672-4095. BRCA1D672-4095 is generated by exclusion of exon 11 by in-frame splicing and produces a 97 kDa protein. In contrast to BRCA1, BRCA1D672-4095 localizes to the cytoplasm.
Protocols
| Product Specific Protocols | |
|---|---|
| IHC protocol for BRCA1 antibody 22362-1-AP | Download protocol |
| IP protocol for BRCA1 antibody 22362-1-AP | Download protocol |
| WB protocol for BRCA1 antibody 22362-1-AP | Download protocol |
| Standard Protocols | |
|---|---|
| Click here to view our Standard Protocols |
Publications
| Species | Application | Title |
|---|---|---|
Mol Cell A di-acetyl-decorated chromatin signature couples liquid condensation to suppress DNA end synapsis | ||
Mol Cell A PARylation-phosphorylation cascade promotes TOPBP1 loading and RPA-RAD51 exchange in homologous recombination.
| ||
Cell Death Differ ZNF451 collaborates with RNF8 to regulate RNF168 localization and amplify ubiquitination signaling to promote DNA damage repair and regulate radiosensitivity | ||
Redox Biol Dysfunction of astrocytic glycophagy exacerbates reperfusion injury in ischemic stroke | ||
Nat Commun SIRT7 is a histone desuccinylase that functionally links to chromatin compaction and genome stability.
| ||
Nucleic Acids Res USP11 acts as a histone deubiquitinase functioning in chromatin reorganization during DNA repair. |
Reviews
The reviews below have been submitted by verified Proteintech customers who received an incentive for providing their feedback.
FH Juhi (Verified Customer) (09-10-2025) | Worked nicely!
|
FH Hasan (Verified Customer) (08-08-2022) | Western blot for HeLa cells transfected with siRNA against BRCA1 or control. anti-BRCA1 Ab (22362-1-AP) was used at dilution of (1:2000) in 5% skimmed milk. incubation overnight at 4 degrees.
![]() |